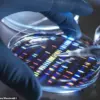
UK Scientists' Synthetic DNA Project Ignites Debate Over Ethical and Regulatory Oversight

Scientists have taken a bold and controversial step toward creating synthetic human DNA from scratch, a move some critics liken to ‘playing God.’ This research, backed by a coalition of leading UK universities, seeks to redefine the boundaries of genetic science.
While proponents argue it could unlock transformative medical advancements, opponents warn of unprecedented ethical and security risks.
The project, which has drawn both acclaim and condemnation from the scientific community, is being conducted under strict oversight, with access to details limited to a select group of researchers and institutional reviewers.
The implications of this work, however, extend far beyond the lab, touching on the very essence of what it means to be human.
The research aims to unlock new treatments for autoimmune disorders, heart failure, viral infections, and age-related diseases.
By constructing DNA from scratch rather than editing existing strands, scientists claim they can achieve a level of precision and control previously unattainable.
This approach allows researchers to test genetic functions in isolation, unbound by the complexities of existing biological systems.
For instance, the team at the University of Cambridge is exploring how to engineer tissues resistant to viruses like HIV, while colleagues at Imperial College London are investigating the potential to repair damaged organs using synthetic DNA as a scaffold.
These experiments, though still in early stages, represent a paradigm shift in how medical science approaches disease.
To do so, scientists are developing tools to build large, complex sections of human DNA in the lab and insert them into skin cells to observe how they function.
This process, known as ‘synthetic genomics,’ involves assembling DNA sequences using programmable DNA synthesis machines.
The ultimate goal is to construct entire human chromosomes, a foundational step toward assembling a fully synthetic human genome.
Such a feat would mark the first time in history that a complete human genome has been created outside the body, raising profound questions about the nature of life, identity, and the responsibilities of those who wield such power.
But the project has sparked ethical and safety concerns.
Experts warn that the technology could have catastrophic risks, leading to biological weapons or genetically engineered ‘designer babies.’ The possibility of misuse is not hypothetical; it is a tangible threat.

Professor Bill Earnshaw of the University of Edinburgh, a vocal critic of the initiative, has warned that ‘the genie is out of the bottle.’ He argues that if an organization with the right equipment decided to start synthesizing anything, ‘I don’t think we could stop them.’ This sentiment is echoed by Dr.
Pat Thomas, a longtime campaigner on genetic ethics, who cautions that while many scientists have good intentions, ‘the science can be repurposed to harm, and even for warfare.’
Every cell in our body, except red blood cells, contains DNA, the molecule that carries the genetic instructions for life.
DNA is composed of just four chemical bases—adenine (A), guanine (G), cytosine (C), and thymine (T)—which repeat in countless combinations to form the code that shapes everything from eye color to disease risk.
The ability to synthesize this code from scratch represents a fundamental breakthrough in molecular biology.
Over the next five years, teams from the University of Oxford, Cambridge, Kent, Manchester, and Imperial College London will collaborate to build and test synthetic DNA in the lab.
Their short-term goal is to better understand how DNA influences human development, health, and aging.
By constructing DNA from scratch, rather than editing existing strands, scientists gain unprecedented control to explore genetic function and test new biological theories.
This research could help uncover how faulty cells trigger disease or lead to the creation of disease-resistant tissues and repair techniques for organs like the heart or liver.
Dr.
Julian Sale of Cambridge’s MRC Laboratory of Molecular Biology, who has been closely involved in the project, told the BBC that the work is ‘about developing therapies that will improve people’s lives as they age, leading to healthier aging with less disease.’ He added that the technology also allows researchers to explore the so-called ‘dark matter’ of the genome—the vast, little-understood regions of DNA that don’t code for proteins but may play critical roles in cellular function.
These non-coding regions, which make up nearly 99% of the human genome, are a frontier of scientific inquiry, and synthetic DNA offers a unique opportunity to study them in isolation.
While medical treatments may still be years away, the work could eventually lead to new therapies, like virus-resistant tissues, lab-grown organs, or advanced cell-based medicine.

Professor Matthew Hurles of the Wellcome Sanger Institute, who has collaborated with the research teams, said the work could revolutionize treatment by revealing why certain cells cause disease and how to fix them.
He emphasized that the ability to construct DNA from scratch allows scientists to ‘test out how DNA really works and test out new theories, because currently we can only do that by tweaking DNA in existing living systems.’ This approach may also lead to advances beyond the human genome, with potential applications in synthetic biology, agriculture, and even energy production.
Philosophy professor Iain Brassington from the University of Manchester highlighted the potential for creating synthetic mitochondria, the cell’s energy powerhouses, which could help women with inherited mitochondrial disorders have children without relying on egg donors.
This innovation, he argued, could be a ‘game-changer’ for families affected by these conditions.
However, Brassington also warns of serious consequences if the technology is misused.
For example, lab-engineered bacteria designed to clean up oil spills or digest plastic could wreak havoc if released into the environment. ‘Such bugs getting into the environment could be catastrophic,’ he said, underscoring the need for stringent safeguards and international cooperation to prevent unintended consequences.
The debate over synthetic DNA is not merely a scientific or medical issue—it is a societal one.
As the technology advances, the question of who controls it, who benefits from it, and who bears the risks becomes increasingly urgent.
While the potential to eradicate disease and extend human lifespan is tantalizing, the ethical and security challenges are equally profound.
The research teams involved in the project have pledged to work transparently and to engage the public in discussions about the future of synthetic genomics.
Yet, as the work progresses, the line between scientific progress and existential risk grows ever thinner.
The world is watching, and the next chapter of this story will be written not just in the lab, but in the choices made by those who hold the power to shape the future.